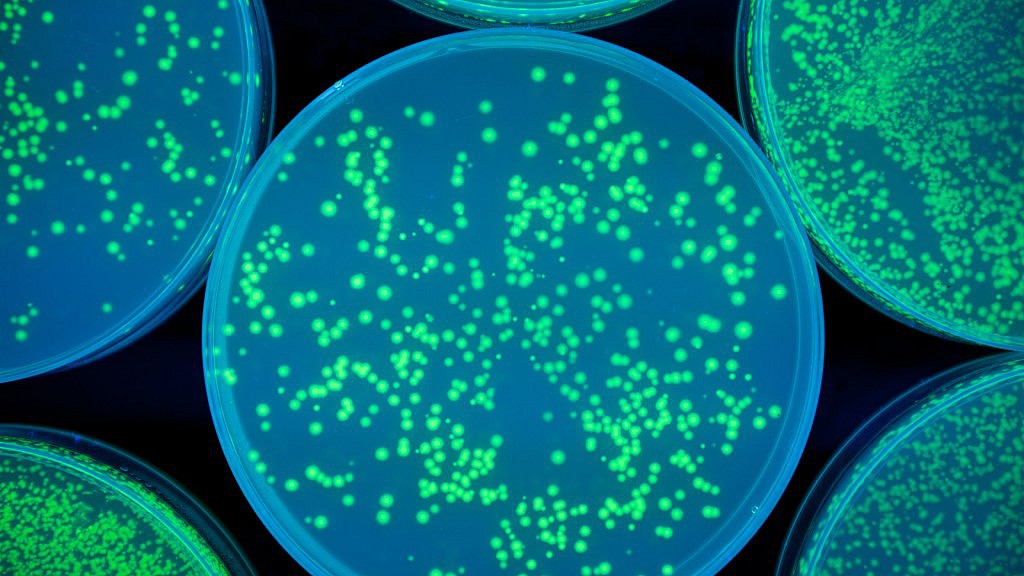

Neil Rowe, Head of Practice at Maulin Law, looks at the recent extension of Martha’s Rule.
Introduction
Last week, NHS England extended Martha’s Rule to all 210 acute hospitals in England, following a successful pilot across 143 sites. This interventional Rule enables patients, families, carers, and even hospital staff to request a rapid independent review by a different clinical team when concerns arise about deteriorating or inadequate care. Since its launch, the Rule has already delivered hundreds of critical, potentially life-saving interventions.
Who Was Martha Mills — and What Happened?
Martha Mills was a 13-year-old girl who, in 2021, suffered a pancreatic injury after a bicycle accident and was admitted to King’s College Hospital, London. She developed sepsis and tragically died — just days before her 14th birthday. A coroner concluded that Martha would likely have survived had she been transferred to paediatric intensive care in time.
Martha’s parents — Merope Mills and Paul Laity — warned that their concerns about her deteriorating condition were repeatedly dismissed. The entrenched culture of medical deference, dismissing parental insights, contributed to the systemic failure that cost Martha her life.
The Advent and Early Implementation of Martha’s Rule
Motivated by grief and a fierce determination for systemic change, Martha’s parents embarked on a campaign to establish a formal right to request a second clinical opinion when concerns go unaddressed. Widely published, Merope’s account catalysed rapid momentum. Within days, the initiative gained cross-party support in Parliament, and by February 2024, NHS England publicly committed to implementing Martha’s Rule.
By April 2024, the rule’s phased rollout had begun: initially targeting 100 acute hospitals with mature critical-care outreach structures. Regulators — GMC, NMC, and CQC — joined in endorsing the principle of listening to patient and family concerns and safeguarding the right to a second opinion.
The policy rests on three core components:
- Daily structured inquiry into patients’ well-being, inviting them or their family/carers to voice any sense of deterioration.
- 24/7 access for staff to request peer review from a different team if concerns escalate.
- 24/7 access for patients, families, and carers to trigger a rapid review — via clearly advertised helplines or escalation processes.
Whilst the Rule originated within and has been implemented in the NHS, the principles upon which it is based are equally applicable to the independent sector and so it is expected that the Rule should apply also in private hospitals.
Early Impact: Pilot Phase Results
Data from the pilot phase (September 2024 through June 2025) show nearly 4,906 calls were logged across 143 pilot hospitals. About 72% of these originated from families.
These escalations triggered:
- 241 potentially life-saving interventions, including 93 urgent ICU or HDU admissions and 49 transfers to enhanced care or tertiary centres.
- 720 care changes, such as starting antibiotics or arranging specialist imaging.
- 794 interventions addressing delays in clinical actions like investigations or medication.
- 1,030 cases resolved around communication or discharge planning.
The 4 September 2025 Expansion: What It Means for Patients
On 4 September 2025, on what would have been Martha’s 18th birthday, NHS England officially rolled out Martha’s Rule to all 210 acute hospitals in England. The decision was grounded in the clear success of the pilot.
Parents Merope and Paul called it “a landmark moment” and emphasized the hope that every patient in the UK will know of and access the Rule. The policy is now also being trialled in maternity, neonatal, emergency, community, and mental health settings.
NHS England’s National Medical Director, Professor Meghana Pandit, described the Rule’s “transformative impact” on how hospitals collaborate with patients and families to respond to deterioration.
Impact on Clinical Negligence Claims
For lawyers, risk managers, and indemnifiers, Martha’s Rule carries significant implications in clinical negligence. By embedding a formal escalation process grounded in real-time awareness of patient risk, hospitals can better defend against allegations of failure to act. Key impacts include:
• Stronger documentation of care decisions and challenges, showing that concerns were surfaced and addressed promptly.
• Potential for faster resolution of near-miss events, reducing litigation exposure.
• Greater shared responsibility culture — where staff and families engage proactively, minimizing omissions or late escalation.
• Mitigation of reputational risk, as patient safety becomes demonstrably stakeholder-inclusive.
Certainly, the positive statistics seen to date suggest that the Rule should reduce overall the number of complaints and claims that might arise in situations where the Rule applies.
Practical Steps
To fully embed and sustain Martha’s Rule, the following actions are recommended:
- Visibility & Awareness
o Display posters and leaflets across all departments, wards, and waiting areas.
o Incorporate information into admission materials and discharge summaries. - Staff Training & Culture Change
o Train all levels of staff on how to respond to escalations.
o Promote a culture that values family/carer insight, flattens hierarchy, and fosters psychological safety. - Clear Escalation Procedures
o Define clear steps: whom to call, response time expectations, and documentation standards.
o Ensure seamless coordination between outreach, ICU, and ward teams. - Governance & Monitoring
o Include Martha’s Rule in existing patient safety metrics.
o Log calls, categorize responses, and audit impact quarterly.
o Escalations should be followed by debriefs and learning reviews. - Extension Beyond Acute Settings
o Pilot and assess adaptation of the rule for maternity, neonatal, and emergency care.
o Implementation across the independent sector. - Regular Stakeholder Feedback
o Survey patients, families, and staff on awareness, satisfaction, and experience with the Rule.
o Involve patient safety charities to audit fairness and equity across vulnerable populations.
Opportunities for Improvement
While Martha’s Rule has been hugely successful, there is room to strengthen its future:
- Timeliness of data transparency: Monthly data began from September 2025; more frequent insights (even real-time dashboards) could enhance responsiveness.
- Wider geographic rollout: NHS Scotland, Wales, and Northern Ireland would benefit from adopting similar approaches.
- Extension beyond Acute Hospitals: into mental health, community, primary care and General Practice.
- Digital innovation: Integrate escalation triggers into electronic health records, mobile apps, or patient portals to reduce dependence on physical signage or staff recall.
- Equity in access: Ensure materials are accessible in multiple languages and formats (e.g., visual/audio), and mindful of those with disabilities or cognitive impairment.
- Staff workload management: Recognizing concerns about workforce capacity, ensure that outreach teams are adequately resourced to handle surge calling volume.
Conclusion
The extension of Martha’s Rule marks a defining moment in patient safety in the NHS. What began as a tragic injustice for one family — the death of Martha Mills — has evolved into a system-wide safeguard, realigning dynamics for staff to better listen, respond, and act when a patient’s condition worsens.
By formalising the right to an independent clinical review, hospitals are not just averting preventable deaths — they are building a culture of responsiveness, shared accountability, and compassion. Martha’s Rule offers an opportunity to strengthen care quality, reduce avoidable harm, decrease the number of complaints and claims, and foster trust in an increasingly pressured healthcare environment.
With continued refinement, transparent monitoring, and equitable access, Martha’s Rule promises to be more than a legacy — it is a catalyst for more humane, safer, and inclusive healthcare.